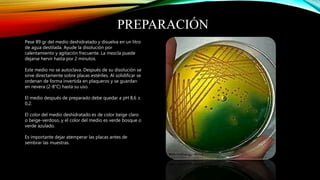
PREPARACIÓN
Pese 89 gr del medio deshidratado y disuelva en un litro
de agua destilada. Ayude la disolución por
calentamiento y agitación frecuente. La mezcla puede
dejarse hervir hasta por 2 minutos.
Este medio no se autoclava. Después de su disolución se
sirve directamente sobre placas estériles. Al solidificar se
ordenan de forma invertida en plaqueros y se guardan
en nevera (2-8°C) hasta su uso.
El medio después de preparado debe quedar a pH 8,6 ±
0,2.
El color del medio deshidratado es de color beige claro
o beige-verdoso, y el color del medio es verde bosque o
verde azulado.
Es importante dejar atemperar las placas antes de
sembrar las muestras.
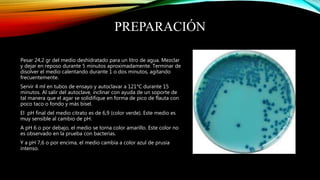
PREPARACIÓN
Pesar 24,2 gr del medio deshidratado para un litro de agua. Mezclar
y dejar en reposo durante 5 minutos aproximadamente. Terminar de
disolver el medio calentando durante 1 o dos minutos, agitando
frecuentemente.
Servir 4 ml en tubos de ensayo y autoclavar a 121°C durante 15
minutos. Al salir del autoclave, inclinar con ayuda de un soporte de
tal manera que el agar se solidifique en forma de pico de flauta con
poco taco o fondo y más bisel.
El pH final del medio citrato es de 6,9 (color verde). Este medio es
muy sensible al cambio de pH.
A pH 6 o por debajo, el medio se torna color amarillo. Este color no
es observado en la prueba con bacterias.
Y a pH 7,6 o por encima, el medio cambia a color azul de prusia
intenso.

Este documento describe la funcionalidad y preparación de varios agares y caldos comúnmente usados en microbiología. El Agar TCBS se usa para aislar Vibrio cholerae y otras especies de Vibrio. El Agar TSI sirve como prueba bioquímica inicial para bacilos gram negativos basada en la fermentación de azúcares. El Caldo Urea detecta la presencia de la enzima ureasa producida por ciertos microorganismos. Cada medio se prepara disolviendo el deshidratado en